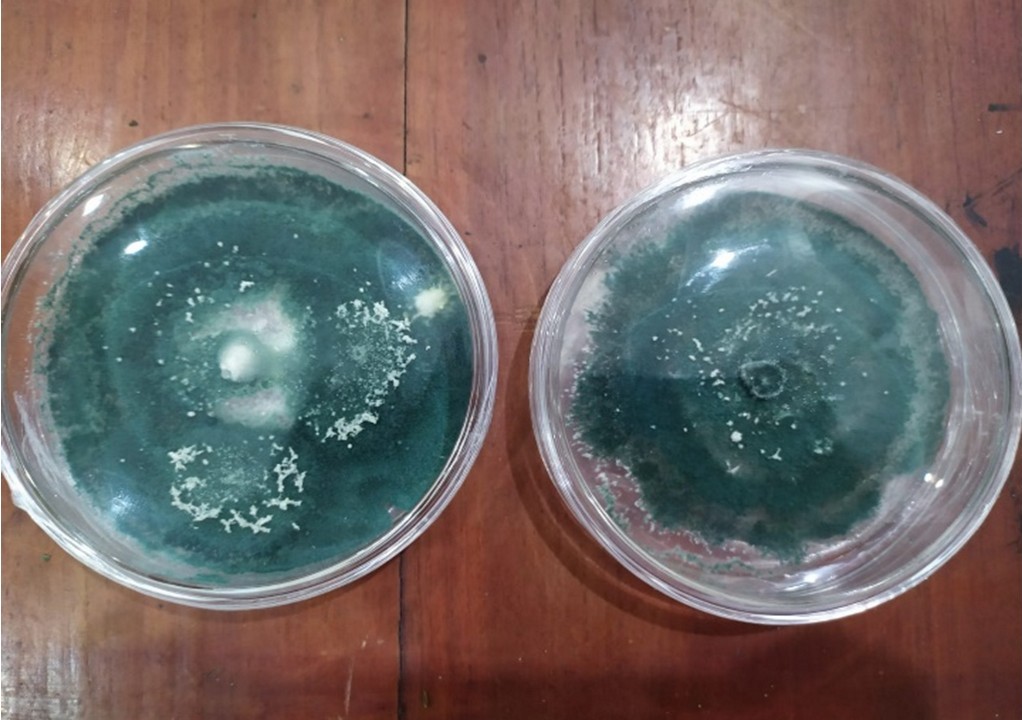

PEMANFAATAN TRICHODERMA SPP. SEBAGAI UPAYA PENGENDALIAN OPT RAMAH LINGKUNGAN
PEMANFAATAN
TRICHODERMA SPP. SEBAGAI UPAYA PENGENDALIAN OPT RAMAH LINGKUNGAN
Oleh:
Pande Made Giopany, S.P.
(POPT
– Ahli Pertama BPP Kecamatan Sukasada)
Organisme Pengganggu Tumbuhan (OPT) merupakan salah satu
tantangan petani dalam usaha budidaya pertanian. Adanya gangguan OPT
menyebabkan menurunnya hasil panen secara drastik. Selama ini, petani masih
mengandalkan pestisida kimia untuk mengendalikan OPT di lapangan. Namun,
penggunaan pestisida kimia secara berlebihan dapat menimbulkan masalah baru,
seperti resistensi hama, pencemaran lingkungan hingga gangguan kesehatan pada
manusia. Upaya yang dapat dilakukan untuk mengurangi dampak negatif tersebut
salah satunya dengan memanfaatkan agens hayati sebagai solusi pengendalian OPT
yang ramah lingkungan.
Salah satu agens hayati yang saat ini telah banyak digunakan
adalah Trichoderma spp., yang yang dikenal sebagai jamur saprofit tanah,
memiliki peran penting sebagai agen hayati dan biofertilisasi, serta mampu
meningkatkan pertumbuhan tanaman dan mengendalikan patogen. Selain sebagai agen
hayati, spesies Trichoderma dapat berperan sebagai organisme pengurai
dan stimulator pertumbuhan tanaman. Beberapa spesies Trichoderma telah dilaporkan
sebagai agensia hayati seperti T. harzianum, T. viridae, dan T.
konigii yang berspektrum luas pada berbagai tanaman pertanian.
Trichoderma spp. melindungi
tanaman melalui beberapa mekanisme utama:
1.
Antibiosis: Trichoderma spp. menghasilkan
senyawa metabolit sekunder yang bersifat antimikroba, mampu menghambat
pertumbuhan atau membunuh patogen tanaman.
2.
Kompetisi: Trichoderma spp. bersaing
dengan patogen untuk mendapatkan ruang dan nutrisi di lingkungan tanah,
sehingga mengurangi peluang patogen untuk berkembang.
3.
Mikoparasitisme: Jamur ini dapat menyerang dan
memparasitisme patogen lain, seperti jamur patogen, dengan cara melilit dan
menembus hifa patogen tersebut, yang akhirnya menyebabkan kematian pada patogen
target.
4.
Induksi Resistensi: Trichoderma spp.
dapat merangsang sistem pertahanan tanaman, meningkatkan ketahanan alami
tanaman terhadap serangan patogen.
Penggunaan Trichoderma spp. sebagai agen hayati telah
terbukti efektif dalam mengendalikan berbagai patogen tular tanah yang
menyerang tanaman pangan dan hortikultura. Beberapa patogen yang dapat
dikendalikan oleh Trichoderma spp. Seperti Ralstonia solanacearum,
Pythium spp., Rhizoctonia solani, Fusarium spp., Botrytis cinerea,
Sclerotium rolfsii, dan Sclerotinia homoeocarpa.
Beberapa penelitian melaporkan bahwa penggunaan pupuk
organik yang dikombinasikan dengan Trichoderma spp. terbukti mampu
meningkatkan pertumbuhan serta hasil panen tanaman. Trichoderma spp.
dengan kemampuannya menghasilkan enzim pendegradasi bahan organik dapat
bersinergi dengan Plant Growth Promoting Rhizobacteria (PGPR), sehingga
pertumbuhan dan produktivitas tanaman menjadi lebih baik. Pengendalian penyakit
tanaman dengan Trichoderma spp. tidak hanya bersifat ramah lingkungan,
tetapi juga efektif dalam menekan pertumbuhan patogen sekaligus mendukung
pertumbuhan vegetatif tanaman.
Sumber Pustaka:
Lehar L, Wardiyati T, Maghfoer MD, Suryanto A. 2016. Selection of
potato varieties (Solanum tuberosum L.) in midlands and the effect of using
biological agents. Int. J.Biosci 9 (3): 129-138.
Purnama, H., Hidayati, N., & Setyowati, E. (2015). Pengembangan
Produksi Pestisida Alami Dari Beauveria Bassianadan Trichoderma Sp. Menuju
Pertanian Organik. Warta LPM, 18(1), 1-9.
Putri, U.D. & Azwir A. 2024. Trichoderma sp: Solusi Ramah
Lingkungan untuk Pengendalian Patogen dan Peningkatan Pertumbuhan Tanaman.
Universitas Negeri Padang. Sumatera Barat
